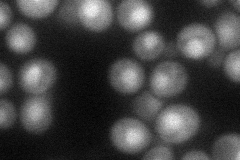
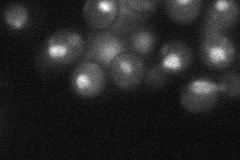

View description
WD40 repeat-containing subunit of the Set3C histone deacetylase complex, which represses early/middle sporulation genes; antagonizes telomeric silencing; binds specifically to the Sir4p N-terminus
Localization:
Intensity:
Fold change:
Significance:
-
C’ GFP library in SD

nucleus22.84 -
N' NOP1pr-GFP in SD

nucleus76.6631 -
N' TEF2pr-mCherry in SD
nucleus56.2624 -
N' NATIVEpr-GFP in SD
nucleus31.509 -
N' TEF2pr-VC and Cyto-VN in SD

punctate,nucleus35.2562 -
C’ GFP library in SD+DTT

nucleus19.70.86No -
C’ GFP library in SD+H2O2

nucleus24.051.05No -
C’ GFP library in Starvation Media

nucleus18.360.8Yes -
C’ GFP library on the background of Pup2-DaMP

nucleus -
C’ GFP library on the background of CCT mutant

nucleus22.90671.00243No
